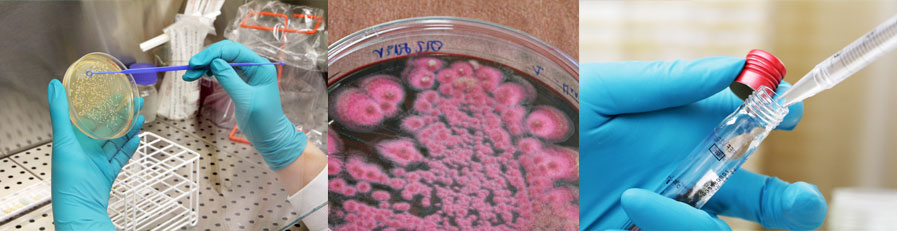
BioPreserv test d'efficacité des produits

Agrément CIR 2017-19
Certifié ISO 9001

BioPreserv propose des prestations de services intégrées : microbiologie, chimie, réglementation
Un interlocuteur unique coordonne les 3 prestations.
Tests en laboratoire
Microbiologie
- Challenge test en pot, en film, normes standards (ISO, CEN, ASTM, NF) ou spécifiques,
- Test d'efficacité antimicrobienne des produits détergents / desinfectants,
- Test d'efficacité antifouling en Laboratoire,
- Test de stérilité microbiologique, contrôle qualité de produits finis ou matières premières,
- Identification de micro-organismes, biologie moléculaire ou biochimie.
Chimie
- Dosage de composants dans un produit formulé (ex : biocides),
- Stabilité chimique des biocides ou autres composants,
- Vieillissement accéléré par la température,
- Résistance au délavage.
Conseil
- Développement de projets R&D sur mesure,
- Analyse des dossiers cosmétiques selon le règlement cosmétique,
- Enregistrement des produits sur le portail de notification CPNP
Expertise réglementaire
- Règlement Cosmétique , Règlement biocide (BPR),
- Aide à la préparation de dossiers :
- Réalisation de dossiers cosmétiques « clé en main » ou « à la carte »,
- Aide à la constitution des dossiers biocides.